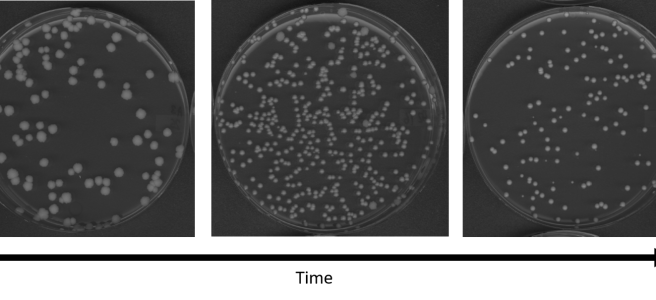

The color red plays an important role in our society: it’s how we know when to stop in traffic, how we see if fruit is ripe, and how we symbolize love. We are so used to seeing the color red that we do not often think about what our lives would be like without it, … Continue reading Red in tooth and claw: primate color vision evolved to see red when there was a shortage of fruit
Embracing differences to boost anti-tumor immunity: How HLA diversity can improve cancer therapy
What if someone tells you that possessing diverse genes could improve your chances of combating infections and even fighting off cancer? The divergent allele advantage hypothesis tries to explain this phenomenon. It states that possessing a greater variety of certain genes (alleles are variants of a gene) can improve individual survival. That would be just … Continue reading Embracing differences to boost anti-tumor immunity: How HLA diversity can improve cancer therapy
“Cystic Fibrosis: A Heterozygote Advantage” – The Title of the Next Hit Movie
By Kelly Bonnville If you’ve ever seen “Five Feet Apart”, a 2019 movie starring Cole Sprouse and Haley Lu Richardson, which tells the dramatic love story of two teenaged cystic fibrosis patients who can never be together due to their disease, you may be under the impression that cystic fibrosis mainly involves not being able … Continue reading “Cystic Fibrosis: A Heterozygote Advantage” – The Title of the Next Hit Movie
Bring on the Heat: The Evolution of Spiciness in Chilies
As someone who likes to play with fire in my cooking, I always have a hearty stock of chili peppers in my kitchen. Depending on the dish, I’ll use anything from canned chipotles, ground cayenne, and paprika to fresh jalapeños and habaneros. All peppers, hot and sweet, are cultivars of five species from the genus … Continue reading Bring on the Heat: The Evolution of Spiciness in Chilies
Global birth canal variation gives insight into human evolutionary past and modern obstetric practices
A recent examination of pelvises from human skeletons indicate migration patterns and climate may be responsible for global variation in birth canal size and shape. This variation likely represents neutral evolution by random chance and not necessarily the selection for pelvic adaptations, challenging long-held theories for human evolution and modern obstetric protocols. You might … Continue reading Global birth canal variation gives insight into human evolutionary past and modern obstetric practices
Seeing red in a new light: Peacock spider courtship defies our human assumptions
How do animals choose their mates? Dr. Maddie Girard and Dr. Damian Elias were pretty sure they knew what female peacock spiders found sexy—it had to be the red. Found throughout Australia, these tiny jumping spiders have excellent vision, and instead of a making a web, they sneak, climb, and pounce to catch their food. … Continue reading Seeing red in a new light: Peacock spider courtship defies our human assumptions
Beer, snowflakes, and the origins of life
The craft beer movement gave rise to an immense diversity of brews. From porters and pale ales to dubels and dunkels, there is a seemingly infinite supply of tasty adult beverages to enjoy. Even within the ales, beer drinkers can choose among ambers, blondes, browns, coffees, and creams. Each of these brews is defined by … Continue reading Beer, snowflakes, and the origins of life
Marine mammals and the legacy of gene loss: evolutionary biology informs policy
Life began in the water. Microbes swarmed around in primordial ooze, banded together to form multicellular organisms, and eventually grew complex enough to leave their watery homes and become the terrestrial animals that exist today. Some of those land-dwelling creatures became mammals, and in a surprising twist, three separate lineages of ancient mammals then returned … Continue reading Marine mammals and the legacy of gene loss: evolutionary biology informs policy
Lessons from the Urban Pigeon
There is an entire community of pigeon collectors living amongst us. They marvel at the diversity of plumage, color, and patterning that this single species displays. In fact, none other than Charles Darwin himself fancied the pigeon species. These pigeon enthusiasts understand that we can learn a lot from pigeon diversity. In a recent publication, … Continue reading Lessons from the Urban Pigeon
New firefly breeding patterns light the way for changes in color vision
A staple of warm summer nights, fireflies have charmed generations with their magical evening glow. Children setting out to capture them in jars can tell you the trick is to catch sight of each flash of light as the bugs fly around. What we might not realize as children is that fireflies emit their greenish … Continue reading New firefly breeding patterns light the way for changes in color vision